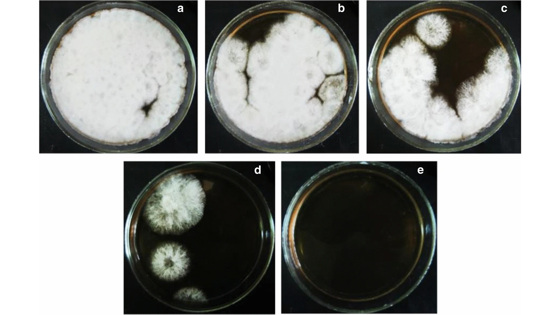

Мицелиальный гриб помог увеличить синтез лекарства для лечения болезней печени
Российские ученые предложили микробиологический метод, позволяющий эффективно синтезировать урсодезоксихолевую кислоту — препарат, который широко используется при лечении различных заболеваний печени. Традиционно ее получают в процессе сложных химических реакций, которые малоэффективны и экологически небезопасны. Авторы «научили» мицелиальный гриб, способный вызывать болезни зерновых культур, синтезировать урсодезоксихолевую кислоту из вещества-предшественника с выходом до 88%. Такой подход позволит упростить и удешевить производство важного для медицины соединения. Результаты исследования, поддержанного грантом Российского научного фонда (РНФ), опубликованы в журнале AMB Express.
Урсодезоксихолевая кислота — лекарственное средство, используемое в современной медицине для лечения и профилактики хронических, воспалительных заболеваний печени, к которым относятся гепатит и цирроз, а также для растворения камней в желчном пузыре. Кроме того, препарат предотвращает развитие рака толстой кишки.
На сегодняшний день урсодезоксихолевую кислоту в промышленных масштабах производят химически, но этот процесс сложен, экологически небезопасен и малоэффективен — лишь 30% вещества-предшественника превращается в нужное соединение. Ученые разрабатывают альтернативные способы получения урсодезоксихолевой кислоты, и наиболее перспективно с этой точки зрения использование микроорганизмов-продуцентов, которые способны ее синтезировать.
Ранее биотехнологи из Института биохимии и физиологии микроорганизмов имени Г. К. Скрябина Пущинского научного центра биологических исследований РАН (Пущино) исследовали способность различных микроскопических грибов синтезировать урсодезоксихолевую кислоту из вещества-предшественника (литохолевой кислоты) и выявили наиболее перспективный штамм гриба Gibberella zeae, также известного как фузариум злаковый, обладающий высокой активностью фермента, необходимого для такого превращения. Использование этого штамма позволяет получать целевой продукт в одну биотехнологическую стадию с двукратным увеличением выхода по сравнению с химическим синтезом.
В новой работе авторам удалось повысить продуктивность грибной культуры в синтезе урсодезоксихолевой кислоты до 88%. Для этого исследователи получили мутантные штаммы с повышенной активностью. Ученые разработали оригинальную процедуру получения протопластов — клеток гриба, не имеющих клеточной стенки. Активно растущий мицелий, или тело гриба, на подходящей питательной среде обработали специальными ферментами, разрушающими клеточную стенку. Это было необходимо для последующего мутагенеза с помощью ультрафиолетового облучения и для получения мутантных клонов с большим числом случайных мутаций, среди которых оказалась бы нужная. В результате эксперимента авторы выявили 27 клонов, три из которых синтезировали на 10-30% больше урсодезоксихолевой кислоты, чем исходные клетки родительского штамма.
«Мы определили оптимальные условия для роста и получения протопластов грибной культуры Gibberella zeae и их мутагенеза. Это позволило значительно повысить эффективность микробиологического синтеза урсодезоксихолевой кислоты. В дальнейшем мы планируем определить ген, ответственный за синтез фермента, катализирующего ключевую реакцию этого процесса. Это позволит изучить его молекулярные механизмы, а также условия, способствующие дальнейшему увеличению продуктивности грибной культуры», — рассказывает руководитель проекта, поддержанного грантом РНФ, Марина Донова, доктор биологических наук, профессор, главный научный сотрудник Института биохимии и физиологии микроорганизмов имени Г. К. Скрябина Пущинского научного центра биологических исследований РАН.
Текст подготовлен Виталиной Власовой